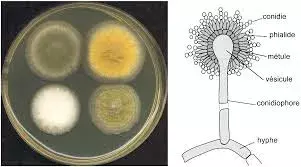
Aspergillus:  వాతావరణ మార్పులతో విస్తరిస్తున్న ఆస్పర్‌జిల్లస్ ఫంగస్

- Home
- /
- #climate change

#climate change
Get Latest News, Breaking News about #climate change. Stay connected to all updated on #climate change
ఆందోళన రేకెత్తిస్తున్న అకాల పుష్పాలు.. వాతావరణ సంక్షోభానికి సంకేతాలు
- By 28 Feb 2024 2:59 PM IST
వావ్ 'ఆకుపచ్చ ఆల్గే' ఎంత అందంగా ఉంది.. అండమాన్ ద్వీపంలో గుర్తించిన కొత్త మొక్క జాతులు
- By 19 Aug 2021 11:02 AM IST
© Copyright 2025 : tv5news.in. All Rights Reserved. Powered by hocalwire.com